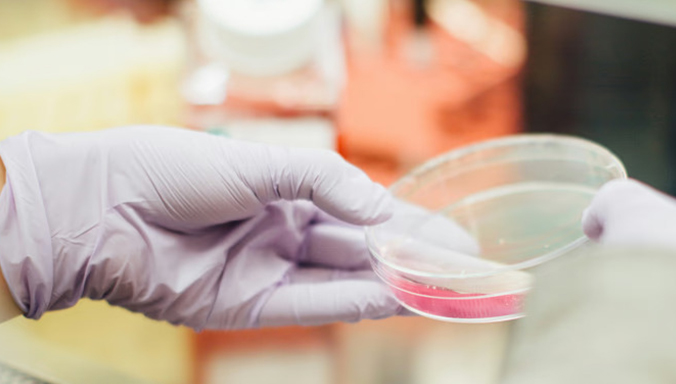

Θεραπευτικές Μέθοδοι
Εξειδικευμένη Φροντίδα για την Υγεία σας
Προσφέρουμε ένα ολοκληρωμένο φάσμα ολιστικών υπηρεσιών που στοχεύουν στην αποκατάσταση της φυσικής ισορροπίας του οργανισμού σας.
Θέλετε Εξατομικευμένη Θεραπεία;

Γενικός Ιατρός - Ομοιοπαθητικός
Γνωρίστε τη Δρ. Φωτεινή Βαλσαμίδου
Με πολυετή εμπειρία στην ιατρική επιστήμη, η Δρ. Βαλσαμίδου εξειδικεύεται στην κλασική ομοιοπαθητική και τον βελονισμό. Η προσέγγισή της είναι ολιστική, αντιμετωπίζοντας τον ασθενή ως μια ενιαία οντότητα σώματος και ψυχής, με στόχο την ουσιαστική και μόνιμη ίαση.
Πτυχίο Ιατρικής
Eιδικός Γενικής Ιατρικής
Εξειδίκευση στην Ομοιοπαθητική & τον Βελονισμό
Πάνω από 20 χρόνια εμπειρίας
Γιατί να μας επιλέξετε
Αφοσίωση στην Ολιστική Θεραπεία & τον Άνθρωπο
Στόχος μας είναι η ουσιαστική ίαση μέσα από μια εξατομικευμένη προσέγγιση που συνδυάζει την ιατρική επιστήμη με τη δύναμη της φύσης.
Η Θεραπευτική Διαδρομή
Ακολουθούμε μια δομημένη διαδικασία για να διασφαλίσουμε το καλύτερο δυνατό αποτέλεσμα για εσάς.
01.
Αρχική Αξιολόγηση &
Ιστορικό
Αφιερώνουμε χρόνο για να κατανοήσουμε το πλήρες ιατρικό σας ιστοικό, τον τρόπο ζωής και τις μοναδικές ανάγκες του οργανισμού σας.
02.
Εξατομικευμένη Ολιστική Προσέγγιση
Σχεδιάζουμε το δικό σας πλάνο που μπορεί να περιλαμβάνει Ομοιοπαθητική, Βελονισμό ή συνδιασμό μεθόδων για την επαναφορά της ισορροπίας.
03.
Διαρκής Υπόστήριξη & Εξέλιξη
Παρακολουθούμε στενά την πρόοδό σας και προσαρμόζουμε τη θεραπεία μέχρι την πλήρη αποκατάσταση της υγείας σας.
Testimonials
Τι λένε οι ασθενείς μας
Κάθε άνθρωπος που μας εμπιστεύεται είναι μια ξεχωριστή περίπτωση. Είτε αναζητάτε λύση σε ένα χρόνιο πρόβλημα, είτε θέλετε να βελτιώσετε τη ζωτικότητά σας, είμαστε εδώ για να σχεδιάσουμε μαζί το δρόμο για τη δική σας ισορροπία.
Αρθρογραφία
Οδηγός Ολιστικής Υγείας
Γνώση για την υγεία σας, έμπνευση για τη ζωή σας!